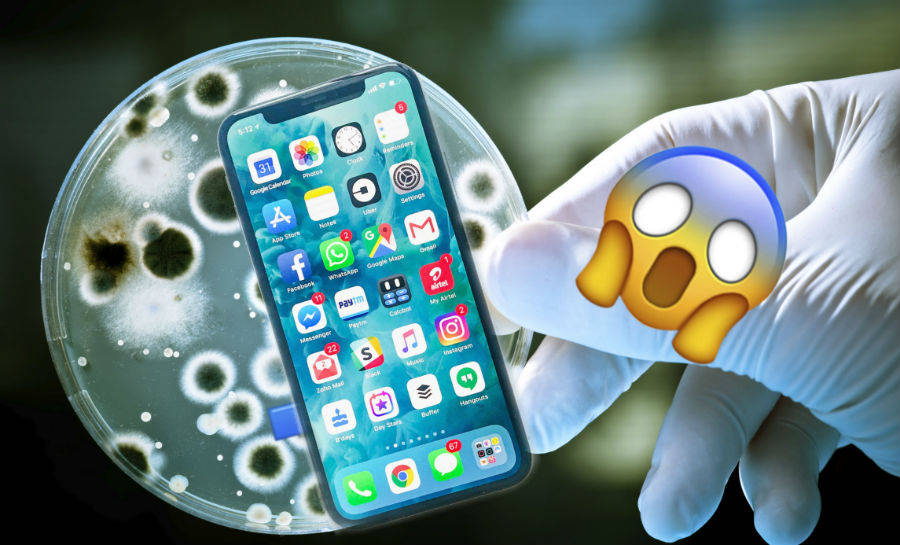
how to track live status new announcement in india on Coronavirus updates covid 19 outbreak

चीन से शुरु हुआ CoronaVirus से इस समय लगभग पूरी दुनिया को प्रभावित हो रही है। कोरोना वायरस का असल दूसरी इंडस्ट्री कके साथ ही स्मार्टफोन इंडस्ट्री पर देखने को मिला है। COVID-19 संक्रमण के कारण फरवरी महीने में स्मार्टफोन शिपमेंट्स में तेजी से गिरावट दर्ज की गई है।
38 प्रतिशत गिरी सेल
सामने आई एक रिपोर्ट के अनुसार पिछले साल फरवरी में स्मार्टफोन मार्केट की परफॉर्मेंस के मुकाबले इस साल स्मार्टफोन्स की सेल काफी कम रही है और इसका सीधा कारण कोरोना वायरस को माना जा रहा है। रिपोर्ट के अनुसार ग्लोबल शिपमेंट फरवरी महीने में 6.1 करोड़ यूनिट्स रही थी। इस तरह पिछले साल के मुकाबले सेल में 38 प्रतिशत की कमी देखी गई थी।
वहीं, अगर बात करें पिछले साल 2019 की तो इस साल फरवरी में 9.9 करोड़ स्मार्टफोन्स की सेल देखने को मिली थी। स्मार्टफोन मार्केट में यह स्थिति का कसूरवार COVID-19 महामारी को बताया जा रहा है। इसी वायरस के कारण स्मार्टफोन कंपनियां भी नए डिवाइस लॉन्च इवेंट्स करने के बजाय ऑनलाइन ही लॉन्च कर रहे हैं।
स्मार्टफोन्स की सेल डेट आगे बड़ी
इसके अलावा कुछ कंपनियों ने अपने फोन्स की सेल डिटेल को आगे बढ़ा दिया है। इसे में शाओमी और रियलमी जैसी कंपनियां भी शामिल हैं। इसके अलावा वीवो ने इंडिया में लॉन्च होने वाले वीवो वी19 की लॉन्चिंग को टाल दिया है। यह लॉन्च 26 मार्च को इंडिया में ऑनलाइन प्लेटफॉर्म पर होना था।
2019 रहा था अच्छा
बाता दें कि जनवरी में चीन में स्मार्टफोन मैन्युफैक्चरिंग पर रोक लगानी पड़ी थी। इस का असर बड़ी कंपनियों की सप्लाई चेन पर पड़ा था। ग्लोबल मार्केट में जहां ऐपल और शाओमी जैसी कंपनियां 2019 के आखिर तक अच्छा परफॉर्म कर रही थीं, 2020 की शुरुआत में उनकी सेल पर भी असर पड़ा है।
इंडिया में बंद हुए मैन्युफैक्चरिंग प्लांट
गौरतलब है कि इंडिया में भी कई कंपनियों ने अपने मैन्युफैक्चरिंग प्लानंट को बंद कर दिया है। साउथ कोरियन टेक कंपनी सैमसंग ने अपने नोएडा स्थित सबसे बड़े प्लांट को कुछ दिनों के लिए शट डाउन कर दिया है।
इंडिया हुआ लॉकडाउन
सैमसंग के अलावा भारत में ओप्पो, वीवो और एलजी के भी प्लांट हैं, जिसे कंपनियां कुछ समय के लिए बंद कर दिया है। दूसरी ओर सरकार ने आज यानी 25 मार्च से 21 दिनों के लॉकडाउन का ऐलान किया है। यह लॉकडाउन पूरे देश में लागू होगा।